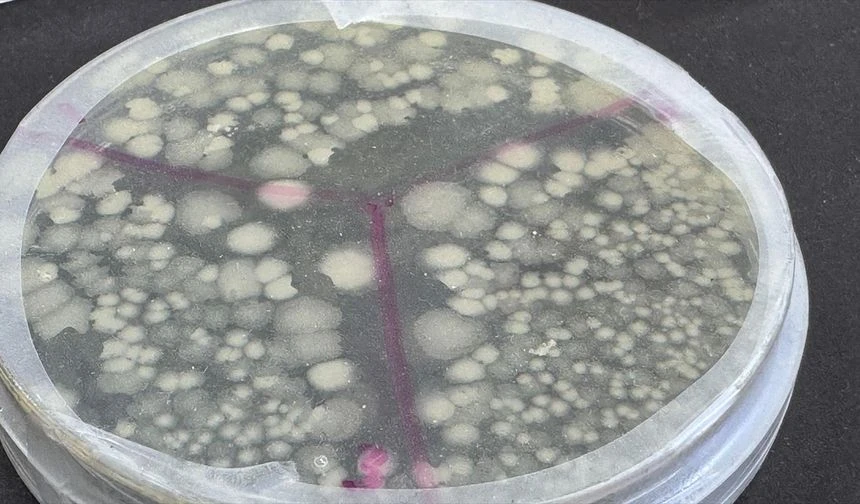
ABD’li bilim insanları, insanlarda nadir görülen bir genetik mutasyondan yola

ABD’li bilim insanları, insanlarda nadir görülen bir genetik mutasyondan yola çıkarak geliştirdikleri deneysel tedaviyle gripten Kovid-19’a kadar birçok virüse karşı koruma sağlayabilecek yeni bir yöntem keşfetti.
Columbia Üniversitesi’nden araştırmacılar, bağışıklık sistemi düzenleyici “ISG15” proteininde eksikliğe yol açan ve az sayıda kişide görülen genetik mutasyonun antiviral etkilerini laboratuvar ortamında taklit etmeyi başardı.
Bilim insanları, geliştirdikleri tedavi yöntemini fareler ve kobaylara burun damlası şeklinde uyguladı. Deneklerde, mutasyonun sağladığına benzer şekilde geçici bir antiviral etki ortaya çıktı. Böylece grip ve Kovid-19’a neden olan virüslerin vücutta çoğalması kısa süreliğine engellendi, hastalığın şiddeti azaldı.
Araştırmacılar, bu yöntemin sadece belirli virüslere değil, tüm virüslere karşı bir koruma kalkanı oluşturabileceğini vurguluyor. Ancak tedavinin sağladığı bağışıklığın süresi henüz kesinleşmiş değil; şu anda etkisinin 3-4 gün sürdüğü tahmin ediliyor.
Çalışmanın ayrıntıları Science Translational Medicine dergisinde yayımlandı.